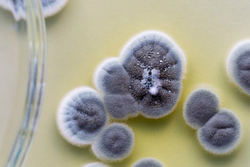

تصور اشتباه در مورد آلرژی به پنیسیلین
بر اساس پژوهشهای اخیر تصور ۹۰ درصد افراد در مورد آلرژی به پنیسیلین با وجود علائمی مثل دانههای پوستی اشتباه است.
بر اساس پژوهشهای اخیر تصور ۹۰ درصد افراد در مورد آلرژی به پنیسیلین با وجود علائمی مثل دانههای پوستی اشتباه است. به گزارش آوای نشاط، این تصور غلط در مورد حساسیت به پنیسیلین در میان بسیاری از افراد رواج دارد و برای سلامتی افراد مضر است. ۱۰ درصد از کل بیماران در ایالات متحده مدعی حساسیت نسبت به پنیسیلین هستند؛ اما تصور ۹۰ درصد آنها اشتباه است.
به همین دلیل میلیونها نفر از آنتیبیوتیکهای جایگزین استفاده میکنند، این آنتیبیوتیکها گرانتر هستند و سلامتی آنها را به خطر میاندازد. راهحل اطمینان از حساسیت، انجام یک آزمایش ساده است. بر اساس بررسی مجلهی پزشکی بریتانیایی (BMJ) روی رکوردهای پزشکی ششسالهی بیماران بریتانیا، افرادی که به پنیسیلین حساسیت دارند، ۷۰ درصد در معرض خطر ویروس استافیلوکوکوس اورئوس مقاوم به متاسیلین (MSRA) و ۲۶ درصد در معرض خطر ویروس کلسترودیوم دیفیسیل (C.diff) قرار دارند.
MRSA و C.diff دو عامل متداول تهدیدکنندهی سلامت انسان هستند. این بررسی افراد مبتلا به حساسیت پنیسیلین را با افرادی با علایم مشابه مقایسه میکند. افرادی که برچسب حساسیت پنیسیلین دارند، معمولا با طیف گستردهای از آنتیبیوتیکها روبهرو میشوند که میتوانند باکتریهای خوب را همراه با باکتریهای بعد از بین ببرند. به این صورت خطر آلوده شدن به MRSA یا C.diff افزایش پیدا میکنند. این دو عفونت در محیط رایجتر هستند و میتوانند بدون هیچ مشکلی روی پوست یا شکم زنده بمانند.
بااینحال اگر آنتیبیوتیکها یک مجموعه از باکتریهای خوب را نابود کنند MRSA و C.diff رشد میکنند و میتوانند مشکلساز شوند. بهگفتهی کیم بلومنتال، مؤلف ارشد این بررسی جدید و استادیار پزشکی در مدرسهی پزشکی هاروارد:
داروهای مرتبط با پنیسیلین در کشتن باکتریها بسیار مؤثر و هدفمند هستند؛ بنابراین بهترین عملکرد را برای کشتن باکتریها دارند. ویروس C.diff پیامدهای بسیار وحشتناکی مثل اسهال شدید، مسمومیت عفونی و حتی مرگ را به دنبال دارد.
بهگفتهی پاول ساکس، رئیس کلینیک بیماریهای مسری در بیمارستان زنان و بیرگام:
همه باید به این درک برسیم که استفاده از آنتیبیوتیک نباید خودسرانه باشد و ریسک زیادی را به دنبال دارد.
ساکس نشان میدهد حساسیت به پنیسیلین رابطهی مستقیم با اقامت طولانیمدت در بیمارستان و افزایش خطر ابتلا به ویروسهای مقاوم دارد. بهگفتهی هلن بوچر، رئیس برنامهی مشارکتی بیماریهای مسری در مرکز پزشکی تافتز:
استفاده از این نوع آنتیبیوتیکها نهتنها برای دنیا، بلکه برای خود بیمار هم مضر است؛ بنابراین میتواند برای همه خطرناک باشد. در مقاومت آنتیبیوتیکی به دلایل پیچیده، صدای تعداد زیادی از بیماران شنیده نمیشود، از طرفی بسیاری از قربانیان هم قبلا جان خود را از دست دادهاند و جایی برای دفاع نمیماند.
ویروسها در برابر بسیاری از داروهای شناختهشده مقاومت میکنند و حتی میتوانند جان انسان را تهدید کنند. به نقل از مراکز کنترل و پیشگیری از بیماریها، ۲ میلیون نفر (تقریبا برابر با جمعیت بروکلین) هر سال به باکتریهای مقاوم آلوده میشوند. بر همین اساس سالانه حداقل ۲۳٬۰۰۰ نفر جان خود را از دست میدهند.
بهگفتهی جاناتان گرین، مدیر بخش همهگیرشناسی (اپیدمولوژی) مرکز پزشکی سدارز سینای لوسآنجلس، تشخیص آلرژیهای پنیسیلین کار دشواری است. نشانههای حساسیت شامل دانههای پوستی، تهوع یا اسهال هستند و ممکن است همزمان با مصرف آنتیبیوتیک رخ دهند. دانههای پوستی مرتب روی بدن کودکان دیده میشود که معمولا با حساسیتهای پنیسیلین اشتباه گرفته میشوند؛ اما به گفتهی ساکس، حتی اگر تشخیصها درست باشند سن آنها متناسب با این حساسیتها نیست.
پس این سؤال به وجود میآید که آلرژی یا حساسیت دقیقا چیست؟ اینترنت پر از پاسخهایی به این سؤالها است و میتوانید با جستوجوی کلمهی خودبیمارانگار یا hypochondriac به آنها برسید اما آلرِژی دقیقا به واکنش ایمنی غیرضروری و افراطی بدن گفته میشود و نشانههای آن میتوانند هر چیزی مثل دانه یا تنفس سخت باشند. گرین میگوید:
بخشی از مشکل اینجاست که آلرژی معانی متفاوتی برای افراد مختلف دارد. مشکل اصلی تشخیص ناتوانیها و آثار جانبی و واکنش آنی است.
برای مثال یکی از بیماران ساکس در اواسط دههی ۲۰ سالگی به یک بیماری قلبی خطرناک مبتلا شد. پنیسیلین میتوانست او را نجات دهد؛ اما سوابق پزشکی او نشان میدادند نسبت به این دارو حساسیت دارد. با پرسوجوی دقیق از تیم پزشکی مشخص شد اگرچه او علائمی مثل تهوع و اسهال را در حین مصرف پنیسیلین داشت اما نسبت به آن آلرژی نداشت.
بر همین اساس بیمارستان آنتیبیوتیک پنیسیلین را برای نجات جان او تجویز کرد. در رابطه با پنیسیلین لازم است بدانید خطرات تشخیص حساسیت گاهی خطرناکتر از علائم خود آلرژی هستند. در اغلب موارد درصورت بروز آلرژی خطرناک و فوری باید از مصرف پنیسیلین اجتناب کرد. بلومنتال میگوید:
در سوابق بیش از ۳۰ میلیون آمریکایی حساسیت به پنیسیلین قید شده است. سعی کنید سوابق پزشکی خود را بررسی کنید. از بیمارانم میخواهم که از خود بپرسند آیا واقعا به پنیسیلین حساسیت دارند یا اینکه به توصیهی مادرشان از مصرف آن خودداری میکنند.
اگر ۱۰ سال از تشخیص حساسیت میگذرد، برای تست مجدد به پزشک مراجعه کنید.
انتهای پیام/
